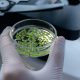
Veganic y Certis Biologicals se unen para distribuir en México tres importantes biosoluciones

Veganic y Certis Biologicals se unen para distribuir en México tres importantes biosoluciones
Veganic aporta su plataforma especializada de comercialización para biosoluciones, respaldada por una red de distribución de biocontrol profundamente arraigada y experta. Por su parte, Certis Biologicals aporta su cartera de productos de referencia y una gran capacidad de innovación en productos biológicos.
México se ha convertido en uno de los mercados agrícolas más importantes de América Latina, con un sector altamente tecnificado y una creciente demanda de soluciones biológicas innovadoras.
Por ello, Veganic compañía dedicada al diseño de productos bioestimulantes y fitosanitarios naturales, 100% orgánicos y veganos, dio un paso más en su estrategia de internacionalización. Recientemente anunció una alianza estratégica con Certis Biologicals para la distribución en México de tres biosoluciones claves de biocontrol.
De acuerdo con la compañía, este acuerdo con Certis Biologicals, una de las empresas líderes mundiales en biopesticidas para la agricultura y la horticultura especializada, no es solo un movimiento comercial: representa un hito para el sector agrícola y refleja la visión compartida de ambas empresas para acelerar la transición hacia una agricultura más sostenible, productiva y rentable.
“Para Veganic, México es una región prioritaria dentro de nuestra expansión internacional, y para Certis Biologicals, representa un territorio estratégico para fortalecer su cartera global. A través de esta alianza, los agricultores mexicanos tendrán acceso a herramientas avanzadas, sostenibles, eficaces y seguras, diseñadas para cumplir con los más altos estándares técnicos y regulatorios”, destacaron mediante un comunicado de prensa.
LA FUERZA DE LA COLABORACIÓN
Lo que hace especial esta alianza es la complementariedad de capacidades. Veganic aporta su plataforma especializada de comercialización para biosoluciones, respaldada por una red de distribución de biocontrol profundamente arraigada y experta.
Por su parte, Certis Biologicals aporta su cartera de productos de referencia y una gran capacidad de innovación en productos biológicos.
De esta manera, la combinación de fortalezas acelerará la distribución en México y sentará las bases para una colaboración a largo plazo que incluirá programas de capacitación técnica, innovación aplicada y proyectos de investigación de campo.
TRES BIOSOLUCIONES ESTRATÉGICAS PARA MÉXICO
ABLE® WP (Reg. N. RSCO-INAC-0105-368-002-004)
Bioinsecticida a base de Bacillus thuringiensis, diseñado para el control eficaz de plagas clave como Spodoptera, Trichoplusia y Helicoverpa.
BACILO-x® LC (reg. N. RSCO-FUNG-0395-X0118-064-98.85)
Biofungicida con Bacillus amyloliquefaciens cepa D747, que presenta múltiples modos de acción contra enfermedades como Botrytis, Phytophthora y Rhizoctonia.
NEEMAZAD® 1% EC (RSCO-INAC-0101B-0333-009-1.0)
Bioinsecticida botánico a base de extracto de Neem, con acción reguladora del crecimiento e inhibidora de la alimentación, eficaz contra trips, moscas blancas, pulgones y minadores de hojas.
Más allá de los productos, esta alianza refleja una misión común: fortalecer el biocontrol de cultivos en todo el mundo. Tanto Veganic como Certis Biologicals comparten el compromiso de proporcionar a los agricultores soluciones fiables, innovadoras y sostenibles, creando valor hoy y construyendo un futuro más resiliente para la agricultura.







